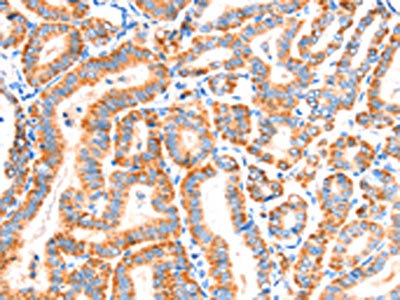

SCNN1A Antibody
-
中文名稱:SCNN1A兔多克隆抗體
-
貨號:CSB-PA435775
-
規(guī)格:¥1100
-
圖片:
-
The image on the left is immunohistochemistry of paraffin-embedded Human thyroid cancer tissue using CSB-PA435775(SCNN1A Antibody) at dilution 1/30, on the right is treated with synthetic peptide. (Original magnification: ×200)
-
The image on the left is immunohistochemistry of paraffin-embedded Human colon cancer tissue using CSB-PA435775(SCNN1A Antibody) at dilution 1/30, on the right is treated with synthetic peptide. (Original magnification: ×200)
-
-
其他:
產(chǎn)品詳情
-
Uniprot No.:
-
基因名:SCNN1A
-
別名:Alpha ENaC 2 antibody; Alpha ENaC antibody; Alpha NaCH antibody; Alpha-ENaC antibody; Alpha-NaCH antibody; Amiloride sensitive epithelial sodium channel alpha subunit antibody; Amiloride sensitive sodium channel subunit alpha antibody; Amiloride-sensitive sodium channel subunit alpha antibody; ENaCA antibody; ENaCalpha antibody; Epithelial Na(+) channel subunit alpha antibody; Epithelial Na+ channel subunit alpha antibody; FLJ21883 antibody; Nonvoltage gated sodium channel 1 subunit alpha antibody; Nonvoltage-gated sodium channel 1 subunit alpha antibody; SCNEA antibody; SCNN 1 antibody; SCNN1 antibody; Scnn1a antibody; SCNNA_HUMAN antibody; Sodium channel nonvoltage gated 1 alpha antibody
-
宿主:Rabbit
-
反應(yīng)種屬:Human
-
免疫原:Synthetic peptide of Human SCNN1A
-
免疫原種屬:Homo sapiens (Human)
-
標記方式:Non-conjugated
-
抗體亞型:IgG
-
純化方式:Antigen affinity purification
-
濃度:It differs from different batches. Please contact us to confirm it.
-
保存緩沖液:-20°C, pH7.4 PBS, 0.05% NaN3, 40% Glycerol
-
產(chǎn)品提供形式:Liquid
-
應(yīng)用范圍:ELISA,IHC
-
推薦稀釋比:
Application Recommended Dilution ELISA 1:2000-1:5000 IHC 1:25-1:100 -
Protocols:
-
儲存條件:Upon receipt, store at -20°C or -80°C. Avoid repeated freeze.
-
貨期:Basically, we can dispatch the products out in 1-3 working days after receiving your orders. Delivery time maybe differs from different purchasing way or location, please kindly consult your local distributors for specific delivery time.
-
用途:For Research Use Only. Not for use in diagnostic or therapeutic procedures.
相關(guān)產(chǎn)品
靶點詳情
-
功能:Sodium permeable non-voltage-sensitive ion channel inhibited by the diuretic amiloride. Mediates the electrodiffusion of the luminal sodium (and water, which follows osmotically) through the apical membrane of epithelial cells. Plays an essential role in electrolyte and blood pressure homeostasis, but also in airway surface liquid homeostasis, which is important for proper clearance of mucus. Controls the reabsorption of sodium in kidney, colon, lung and eccrine sweat glands. Also plays a role in taste perception.
-
基因功能參考文獻:
- In the present study, the SCNN1G gene was associated with 24-h urinary sodium excretion but was not related to blood pressure. The SCNN1A and SCNN1B genes were not associated with blood pressure either. PMID: 29757959
- mutation in the extracellular domain of alphaENaC causes Liddle syndrome by increasing intrinsic channel activity. PMID: 28710092
- The mRNA and alpha-ENaC protein were overexpressed in platelets from hypertensive subjects versus control subjects. PMID: 27137675
- The derlin-1 pathway therefore may represent a significant early checkpoint in the recognition and degradation of ENaC in mammalian cells. PMID: 28137758
- Data show that the expression of aquaporin (AQP) 1, AQP3, AQP5, epithelial Na+ channel (ENaC) and sodium potassium ATPase (Na-K-ATPase) are altered in patients with acute respiratory failure (ARF) due to diffuse alveolar damage (DAD), and the cause of DAD does not seem to influence the level of impairment of these channels. PMID: 27835672
- The data indicate that the Lhs1 chaperone selectively recognizes an immature form of alphaENaC, one which has failed to correctly assemble with the other channel subunits via its transmembrane domain. PMID: 27903760
- LEFTY2 regulates the expression and activity of ENaC in endometrial epithelial cells via SGK1. PMID: 27606670
- Carriage of the p.W493R-SCNN1A polymorphism has been identified as a risk factor for bronchiectasis, but it is not invariably associated with the phenotype of a hyperactive ENaC channel in the lung. PMID: 26453628
- although subgroup analysis showed alpha-ENaC T663A polymorphism was associated with essential hypertension in North American individuals, these meta-analysis results did not confirm such association overall; conclude that Alpha-ENaC T663A polymorphism might not be a risk factor for essential hypertension PMID: 26318459
- Neither bronchodilatory response nor bicycling time trial performance after salbutamol was affected by genotype at rs2228576. PMID: 25894531
- Four nonsynonymous amino acid variants in SCNN1A in nonwhite Cystic fibrosis patients with non-diagnostic CFTR genotypes was identified. PMID: 25900089
- The rs4149570 and rs7956915 polymorphisms of SCNN1A might play important roles in the susceptibility to respiratory distress syndrome, particularly in term infants. PMID: 26611714
- These results indicate that ENaC functions as a sensor for external Cd2+. PMID: 27045669
- The transcriptional expression of alpha, beta, and gamma subunits of ENaC was elevated in nasal polyp compared to nasal mucosa PMID: 25559464
- The long isoform of alphaENaC forms the structural basis of a channel with different activity and regulation, which may not be easily distinguishable in native tissue, but may underlie sodium hyperabsorption and salt sensitive differences in humans. PMID: 25517724
- ENaC regulates miR-101/miR-199a-3p during embryo implantation with the involvement of CREB phosphorylation. PMID: 25187622
- Five de novo mutations were identified in four genes (SCNN1A, KCNJ16, KCNB2, and KCNT1) in three Brugada syndrome patients PMID: 25339316
- ASIC1A and ENaCalpha form functional heterotrimers acting as ion channels. PMID: 26032502
- SCNN1A and SCNN1G SNPs may contribute to blood pressure changes over time in the Han Chinese population. PMID: 24735600
- Skin hydration status regulates sodium homeostasis and inflammatory pathways through the epithelial sodium channel (ENaC). PMID: 25371970
- It essentially participates in regulatory systems of blood pressure and normal gas exchange. PMID: 25242083
- Increased CFTR expression and decreased ENaC-alpha expression in the decidua of early abortion may relate with failure of early pregnancy. PMID: 24914548
- Cystic fibrosis-like disease probably has an oligogenic origin, resulting from mutations in several genes, including CFTR, SERPINA1, and SCNN1 isoforms. PMID: 23837941
- In this study, authors found that miR-125b inhibits hepatitis B virus expression in vitro by regulating SCNN1A expression. PMID: 25173609
- dexamethasone increases the transcript and protein expression of the alpha-, beta-, and gamma-ENaC subunits via the GR-SGK1-Nedd4-2 pathway and provides insight into the molecular mechanism of the increased sodium transport mediated by ENaC PMID: 24114932
- Two novel mutations in the SCNN1A gene causing pseudohypoaldosteronism type 1 have been identified in two unrelated Chinese infants. PMID: 23762408
- ENaC hyperactivity in cystic fibrosis airways is a direct consequence of acidic airway-surface-liquid (ASL) dehydration which can be reversed by raising ASL pH. PMID: 24043776
- found a diminished expression of the three subunits of the ENaC in the membranes of preeclamptic placentas in comparison with the normal ones PMID: 23218889
- WNK4 inhibits ENaC channel activity independently of Nedd4-2-mediated ENaC ubiquitination. PMID: 23594824
- Data indicate that Grp170 (Lhs1 ortholog) coprecipitate with alphaENaC. PMID: 23645669
- Data indicate that pharmacological KvLQT1 and KATP (Kir6.1) inhibition or silencing with siRNAs down-regulated alpha-ENaC expression. PMID: 22406554
- ENaC in the vascular endothelium determines cellular mechanics and hence might participate in the control of vascular function. PMID: 23460285
- None of the NO-donors had a significant effect on the expression of the ENaC subunits in the presence and absence of L-cysteine in cystic fibrosis airway epithelial cells. PMID: 23523754
- The alpha subunit is essential for ENaC function and mutations truncating the pore-forming part of the protein leading to systemic pseudohypoaldosteronism type 1 PMID: 23416952
- enetic variation of SCNN1A differentially affects the diffusing capacity in patients with Cystic fibrosis. PMID: 22776878
- Ubiquitin-specific peptidase 8 (USP8) regulates endosomal trafficking of the epithelial Na+ channel PMID: 23297398
- Data suggest that proteolytic activation of ENaC by plasmin may contribute to Na(+) retention and hypertension in preeclampsia. PMID: 22987920
- study found that rhinovirus (RV) infection of primary human nasal epithelial cells enhanced the expression of CFTR, alpha-ENaC, beta-ENaC, and gamma-ENaC mRNA and protein; upregulated CFTR might be dysfunctional, whereas RV-upregulated ENaC was hyperfunctional PMID: 22374202
- findings suggest that a helical conformation in its carboxyterminal part is functionally important to mediate ENaC inhibition by the alpha-13-mer peptide PMID: 22613977
- G2139A, G3091A, T663A, and T3593C polymorphisms of alphaENaC gene may play an important role in the development of essential hypertension among Kazakhs in Xinjiang. PMID: 20078945
- investigation of control of airway epithelial Na+ absorption via up-regulation/phosphorylation of ENaCalpha, ENaCbeta, and ENaCgamma involving SGK1 (serum-glucocorticoid regulated kinase 1) under control of glucocorticoid/dexamethasone PMID: 22250980
- Multiple residues in the distal C terminus of the alpha-subunit have roles in modulating human epithelial sodium channel activity. PMID: 22573385
- These results indicate a previously undefined role of ENaC in regulating the PGE production and release required for embryo implantation. PMID: 22729284
- Genotype-phenotype correlations and new clinical and genetic entities that may prove relevant for patient's care in neonates with renal salt losing syndromes and/or failure to thrive. PMID: 21664233
- Functional overexpression of voltage-sensitive sodium channel beta-subunits in prostate cancer may be one type of mechanism leading to increased metastatic behavior while decreasing the ability to form localized tumor masses. PMID: 22127840
- A hyperactive variant p.W493R-SCNN1A of the epithelial sodium channel does not necessarily cause CF-like disease in a CF gene carrier, but its low frequency in CF parents suggests that it is a risk factor. PMID: 21917531
- ENaC on motile cilia should be essential for diverse functions of motile cilia, such as germ cell transport, fertilization, implantation, clearance of respiratory airways and cell migration. PMID: 22207244
- genetic variation of the alpha-subunit of ENaC at amino acid 663 influences lung diffusion at peak exercise in healthy humans PMID: 21893217
- genetic variation of ENaC influences beta(2)-adrenergic receptor stimulated Na(+) clearance in the lungs. PMID: 21889619
- large dietary sodium intervention study indicates that common variants of ENaC subunits A,B,G may contribute to the variation of BP response to dietary sodium intake PMID: 21562341
顯示更多
收起更多
-
相關(guān)疾病:Pseudohypoaldosteronism 1, autosomal recessive (PHA1B); Bronchiectasis with or without elevated sweat chloride 2 (BESC2)
-
亞細胞定位:Apical cell membrane; Multi-pass membrane protein. Cell projection, cilium. Cytoplasmic granule. Cytoplasm. Cytoplasmic vesicle, secretory vesicle, acrosome. Cell projection, cilium, flagellum.
-
蛋白家族:Amiloride-sensitive sodium channel (TC 1.A.6) family, SCNN1A subfamily
-
組織特異性:Expressed in the female reproductive tract, from the fimbrial end of the fallopian tube to the endometrium (at protein level). Expressed in kidney (at protein level). In the respiratory tract, expressed in the bronchial epithelium (at protein level). High
-
數(shù)據(jù)庫鏈接:
Most popular with customers
-
-
YWHAB Recombinant Monoclonal Antibody
Applications: ELISA, WB, IHC, IF, FC
Species Reactivity: Human, Mouse, Rat
-
Phospho-YAP1 (S127) Recombinant Monoclonal Antibody
Applications: ELISA, WB, IHC
Species Reactivity: Human
-
-
-
-
-